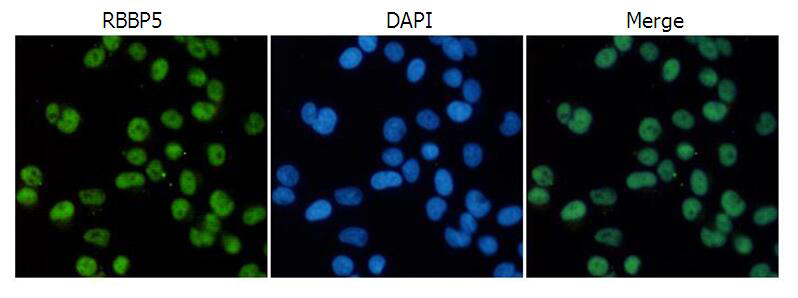
一抗

|
Background: |
This gene encodes a ubiquitously expressed nuclear protein which belongs to a highly conserved subfamily of WD-repeat proteins. The encoded protein binds directly to retinoblastoma protein, which regulates cell proliferation. It interacts preferentially with the underphosphorylated retinoblastoma protein via the E1A-binding pocket B. Three alternatively spliced transcript variants that encode different protein isoforms have been described for this gene. |
|
Applications: |
WB, IF |
|
Name of antibody: |
RBBP5 |
|
Immunogen: |
Fusion protein of human RBBP5 |
|
Full name: |
RB binding protein 5, histone lysine methyltransferase complex subunit |
|
Synonyms: |
RBQ3; SWD1 |
|
SwissProt: |
Q15291 |
|
WB Predicted band size: |
59 kDa |
|
WB Positive control: |
C2C12, THP-1, PC12 and 3T3 cell lysates |
|
WB Recommended dilution: |
1000-5000 |
|
IF positive control: |
Hela cells |
|
IF Recommend dilution: |
50-100 |


 購物車
購物車 幫助
幫助
 021-54845833/15800441009
021-54845833/15800441009